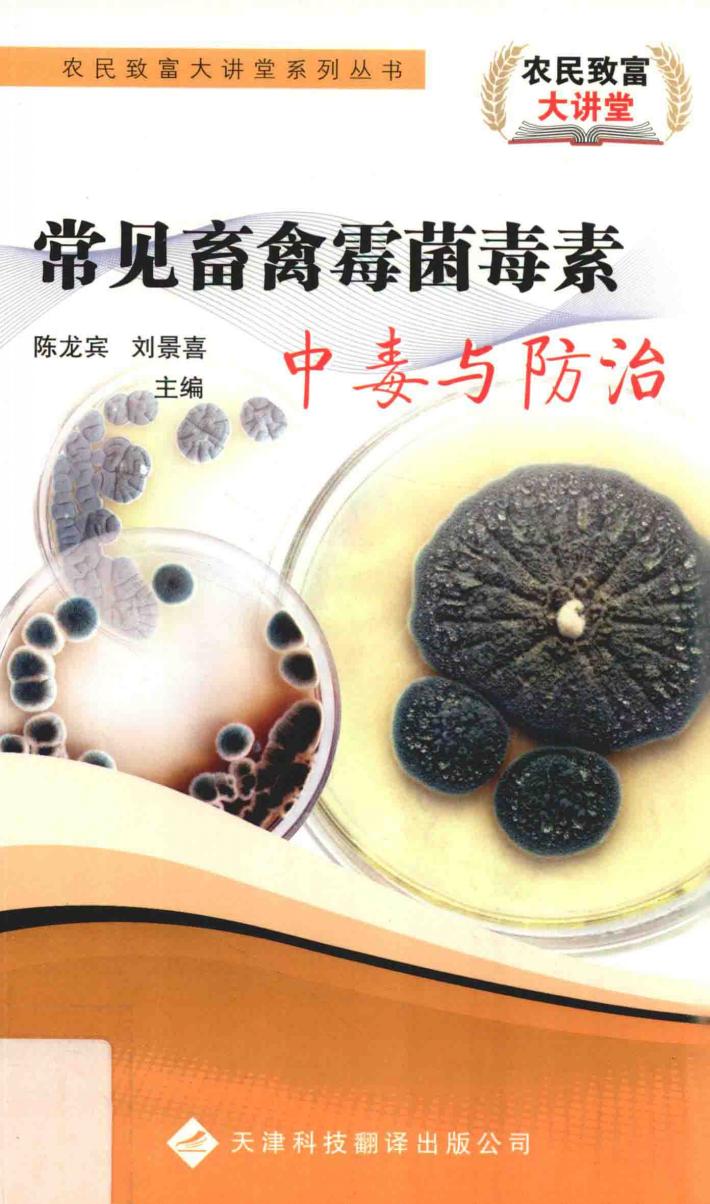
常见畜禽霉菌毒素中毒与防治 封面

常见畜禽霉菌毒素中毒与防治
作者: 陈龙宾,刘景喜主编;潘振亮,韩静,乔家运,范寰,王坤,徐璇,侯振平,于化福,李怀安编;王文杰审定
关键词: 家畜疾病-真菌中毒-防治-禽病
页数:76
出版社: 天津:天津科技翻译出版公司
出版日期:
发现《常见畜禽霉菌毒素中毒与防治》在 2023-03-14 可全文阅读或下载。
图书简介
常见畜禽霉菌毒素中毒与防治
用户须知
出版社通过教客网下载电子书并起诉站长多次,本站随时可能倒闭。
诉讼案号:(2022)川01民初4401,(2022)川01民初4403,(2022)川01民初4403,(2022)川0191民初19351号, (2022)川0191民初19594号,(2022)川0191民初20457号,(2022)川0191民初20459号, (2023)川知民终373号,(2023)川知民终374号,(2023)川知民终375号, (2024)川0191民初15977号,(2024)川0191民初15979号,(2024)川0191民初15980号, (2024)川0191民初15981号,(2024)川0191民初15982号
- 找《常见畜禽霉菌毒素中毒与防治》,去就近图书馆。
- 本页面文字内容和图片来自 m.5read.com。
- 封皮图片引用地址:https://unicover.duxiu.com/coverNew/CoverNew.dll?iid=6567636B696C63686D695AA7A7A09D96A695A6AD5A653135313130303834
